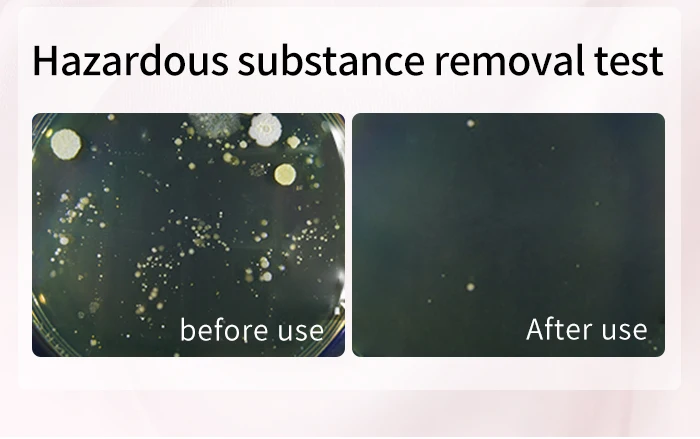

SHVYOG нижнее белье моющее средство частная часть ткань бережная стирка глубокое
Сохраните в закладки:






История цены
*История изменения цены! Указанная стоимость возможно, уже изменилось. Проверить текущую цену - >
| Месяц | Минимальная цена | Макс. стоимость | Цена |
|---|---|---|---|
| Mar-22-2026 | 0.58 руб. | 0.86 руб. | 0 руб. |
| Feb-22-2026 | 0.49 руб. | 0.18 руб. | 0 руб. |
| Jan-22-2026 | 0.80 руб. | 0.47 руб. | 0 руб. |
| Dec-22-2025 | 0.36 руб. | 0.82 руб. | 0 руб. |
| Nov-22-2025 | 0.22 руб. | 0.62 руб. | 0 руб. |
| Oct-22-2025 | 0.87 руб. | 0.59 руб. | 0 руб. |
| Sep-22-2025 | 0.99 руб. | 0.56 руб. | 0 руб. |
| Aug-22-2025 | 0.63 руб. | 0.42 руб. | 0 руб. |
| Jul-22-2025 | 0.91 руб. | 0.8 руб. | 0 руб. |
Новые товары
Новая оригинальная серия Labubu V3 The Monsters Big Into Energy виниловая кукла с лицом модная
Велосипед электрический для взрослых с задним сиденьем и передней корзиной 1000 Вт
Микросхема ANBERNIC RG353V RG353VS 512GB TF карта предварительного загрузки игр PSP DC SS PS1 NDS
ИНСТРУМЕННАЯ ДОСТАВКА НА 4-канальную DJ-систему Pioneer DJ OPUS-QUAD
Кобура в средневековом стиле для пистолета
Устройство чтения карт TF Huawei HuaWei P40mate20/30/40Pro
Автомобильный переключатель регулировки громкости рулевого колеса для VW Jetta 5 MK5 6
Реле RY610024 24V 8A 5PIN
Характеристики
SHVYOG нижнее белье моющее средство частная часть ткань бережная стирка глубокое
Описание товара
Разработан для чистой нижнее белье
Удаляет крови Красители Чистая пятнами; защита от запаха пота Завод очищения Легко краску, не повреждая руки

Вы знаете, как грязное нижнее белье?
В 1964 году д-р Камерон из Великобритании: Кусок грязного нижнего белья со средним содержанием 0,1 граммов фекалий! 10,9 миллионов вирусов в 0,1 г стула Один миллион вредных веществ Тысяча паразитов, обернутых Cai Сто червь яйца

Обычный стиральный порошок Не подходит для чистки нижнего белья Нарушают кислотно-щелочной баланс и вызывают гинекологические болезни Низкая мощность очистки, желтый и жесткий Остаточные вредные вещества, запах при воспалении

Пятна крови, одна капля
Легко удаляет пятна без остатков Глубокий зубные полоски для удаления пятен Завод очищения Нежный рукавицы Дезодорирования

Эффективный, чистый, безопасный и гигиеничный
Папаин разбивает пятна крови Стойкие крови Красители Leucorrhea Выделений


Сохраните ваши личные части обновленными и здоровыми
Растения из оливковых листьев нежные и чистые Предотвратить нашествие вирусов, таких как злобные микроорганизмы и формы E. coli Стафилококк Candida albicans

Мягкий, не повреждая руки
Не раздражает кожу, руки не высыхают после стирки Пушистый и мягкий после стирки Забудьте о к желтому цвету

Пушистый и мягкий после стирки
Забудьте о к желтому цвету

Дезодорирующий натуральный розовый
Успокаивающий и свежий каждый день

Удобный дизайн головки насоса
Легкое касание, удобное извлечение жидкости Один насос одновременно предотвращает перекрестную инфекцию

Информация о продукте
Название продукта: shvyog нижнее белье моющее средство Технические характеристики: 120 мл Основные ингредиенты: лаурилсульфат натрия, папаин, экстракт листьев оливы, экстракт розы, лимонная кислота и др. Эффективность продукта: очистка пятен крови, молочных пятен, мочи и т. Д. Все виды обычных пятен, мягкие и чистые, удаляют запах, сухие и мягкие.

Инструкция по использованию
01 Только ручная стирка Замочите продукт в воде на 20 минут Повторите равномерное Очищение в течение 1-2 минут Краску отлично подойдет в качестве воды 02 стирка в стиральной машине Вылейте изделие прямо на грязь и слегка вотрите его Стирайте одежду в стиральной машине * Пятна крови необходимо замочить в холодной воде, потому что белки в пятнах крови замерзнут при нагревании. * Для стойких пятен вылейте изделие прямо на одежду, смочите его в течение нескольких минут, а затем протрите



Трекер стоимости
Отзывы покупателей
Новые отзывы о товарах
Мне понравился дизайн, нечто похожее недавно видела в бутике. Но там босоножки стоили нереально, а на эти весьма посильная цена.... Читать отзыв полностью...
Всем приветики) Девчонки лосинки огонь! Всем советую! Очень приятные к телу, очень удобные, хорошо тянутся, прекрасно подчеркивают фигуру и срывают... Читать отзыв полностью...
Нарядилась на свадьбу в это платье, и чувствовала себя без преувеличения, королевой. Вблизи оно просто супер - тончайшее кружево, белоснежная... Читать отзыв полностью...
Всем здравствуйте)купил и дочки такую курточку! Очень понравилась! Красивая, теплая, стильная, очень качественно выполнена! Удобные карманчики, очень вместительные!Легк о стирается,... Читать отзыв полностью...
Пару слов хочу сказать о этих монетах, потому как выписала их в подарок племяннику, он уже много лет собирает их.... Читать отзыв полностью...
Заказывала часы сыну в подарок, очень понравилась эта модель. Продавец ответил на все дополнительные вопросы, сразу отправил товар после оплаты.... Читать отзыв полностью...

















Заказывала толстовку для сына. Если честно качество прям удивило, думала придет хуже. Товаром довольна, толстовка теплая стильная, сыну понравилась. С... Читать отзыв полностью...